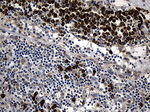
CCDC22 Antibody in Immunohistochemistry (Paraffin) (IHC (P))

Search
OriGene
CCDC22 Monoclonal Antibody (OTI2E4), TrueMAB™
{{$productOrderCtrl.translations['antibody.pdp.commerceCard.promotion.promotions']}}
{{$productOrderCtrl.translations['antibody.pdp.commerceCard.promotion.viewpromo']}}
{{$productOrderCtrl.translations['antibody.pdp.commerceCard.promotion.promocode']}}: {{promo.promoCode}} {{promo.promoTitle}} {{promo.promoDescription}}. {{$productOrderCtrl.translations['antibody.pdp.commerceCard.promotion.learnmore']}}
产品信息
TA811111
种属反应
宿主/亚型
分类
类型
克隆号
抗原
偶联物
形式
浓度
纯化类型
保存液
内含物
保存条件
运输条件
靶标信息
CCDC22 is a recently identified coiled-coil domain-containing protein that has been shown to bind copines, which are calcium-dependent, membrane-binding proteins that may function in calcium signaling. In rat, CCDC22 has been observed to localize in multiple regions of the brain, including the prefrontal and somatosensory cortex, dentate gyrus and thalamus, and in the ipsilateral motor neurons of the spinal cord after sciatic nerve transection suggesting that it may play a role in neuronal injury response. The human CCDC22 gene has been identified as a novel candidate gene for syndromic X-linked intellectual disability (XLID).
仅用于科研。不用于诊断过程。未经明确授权不得转售。
篇参考文献 (0)
生物信息学
蛋白别名: Coiled-coil domain-containing protein 22
基因别名: CCDC22; CXorf37; JM1; RTSC2
UniProt ID: (Human) O60826
Entrez Gene ID: (Human) 28952